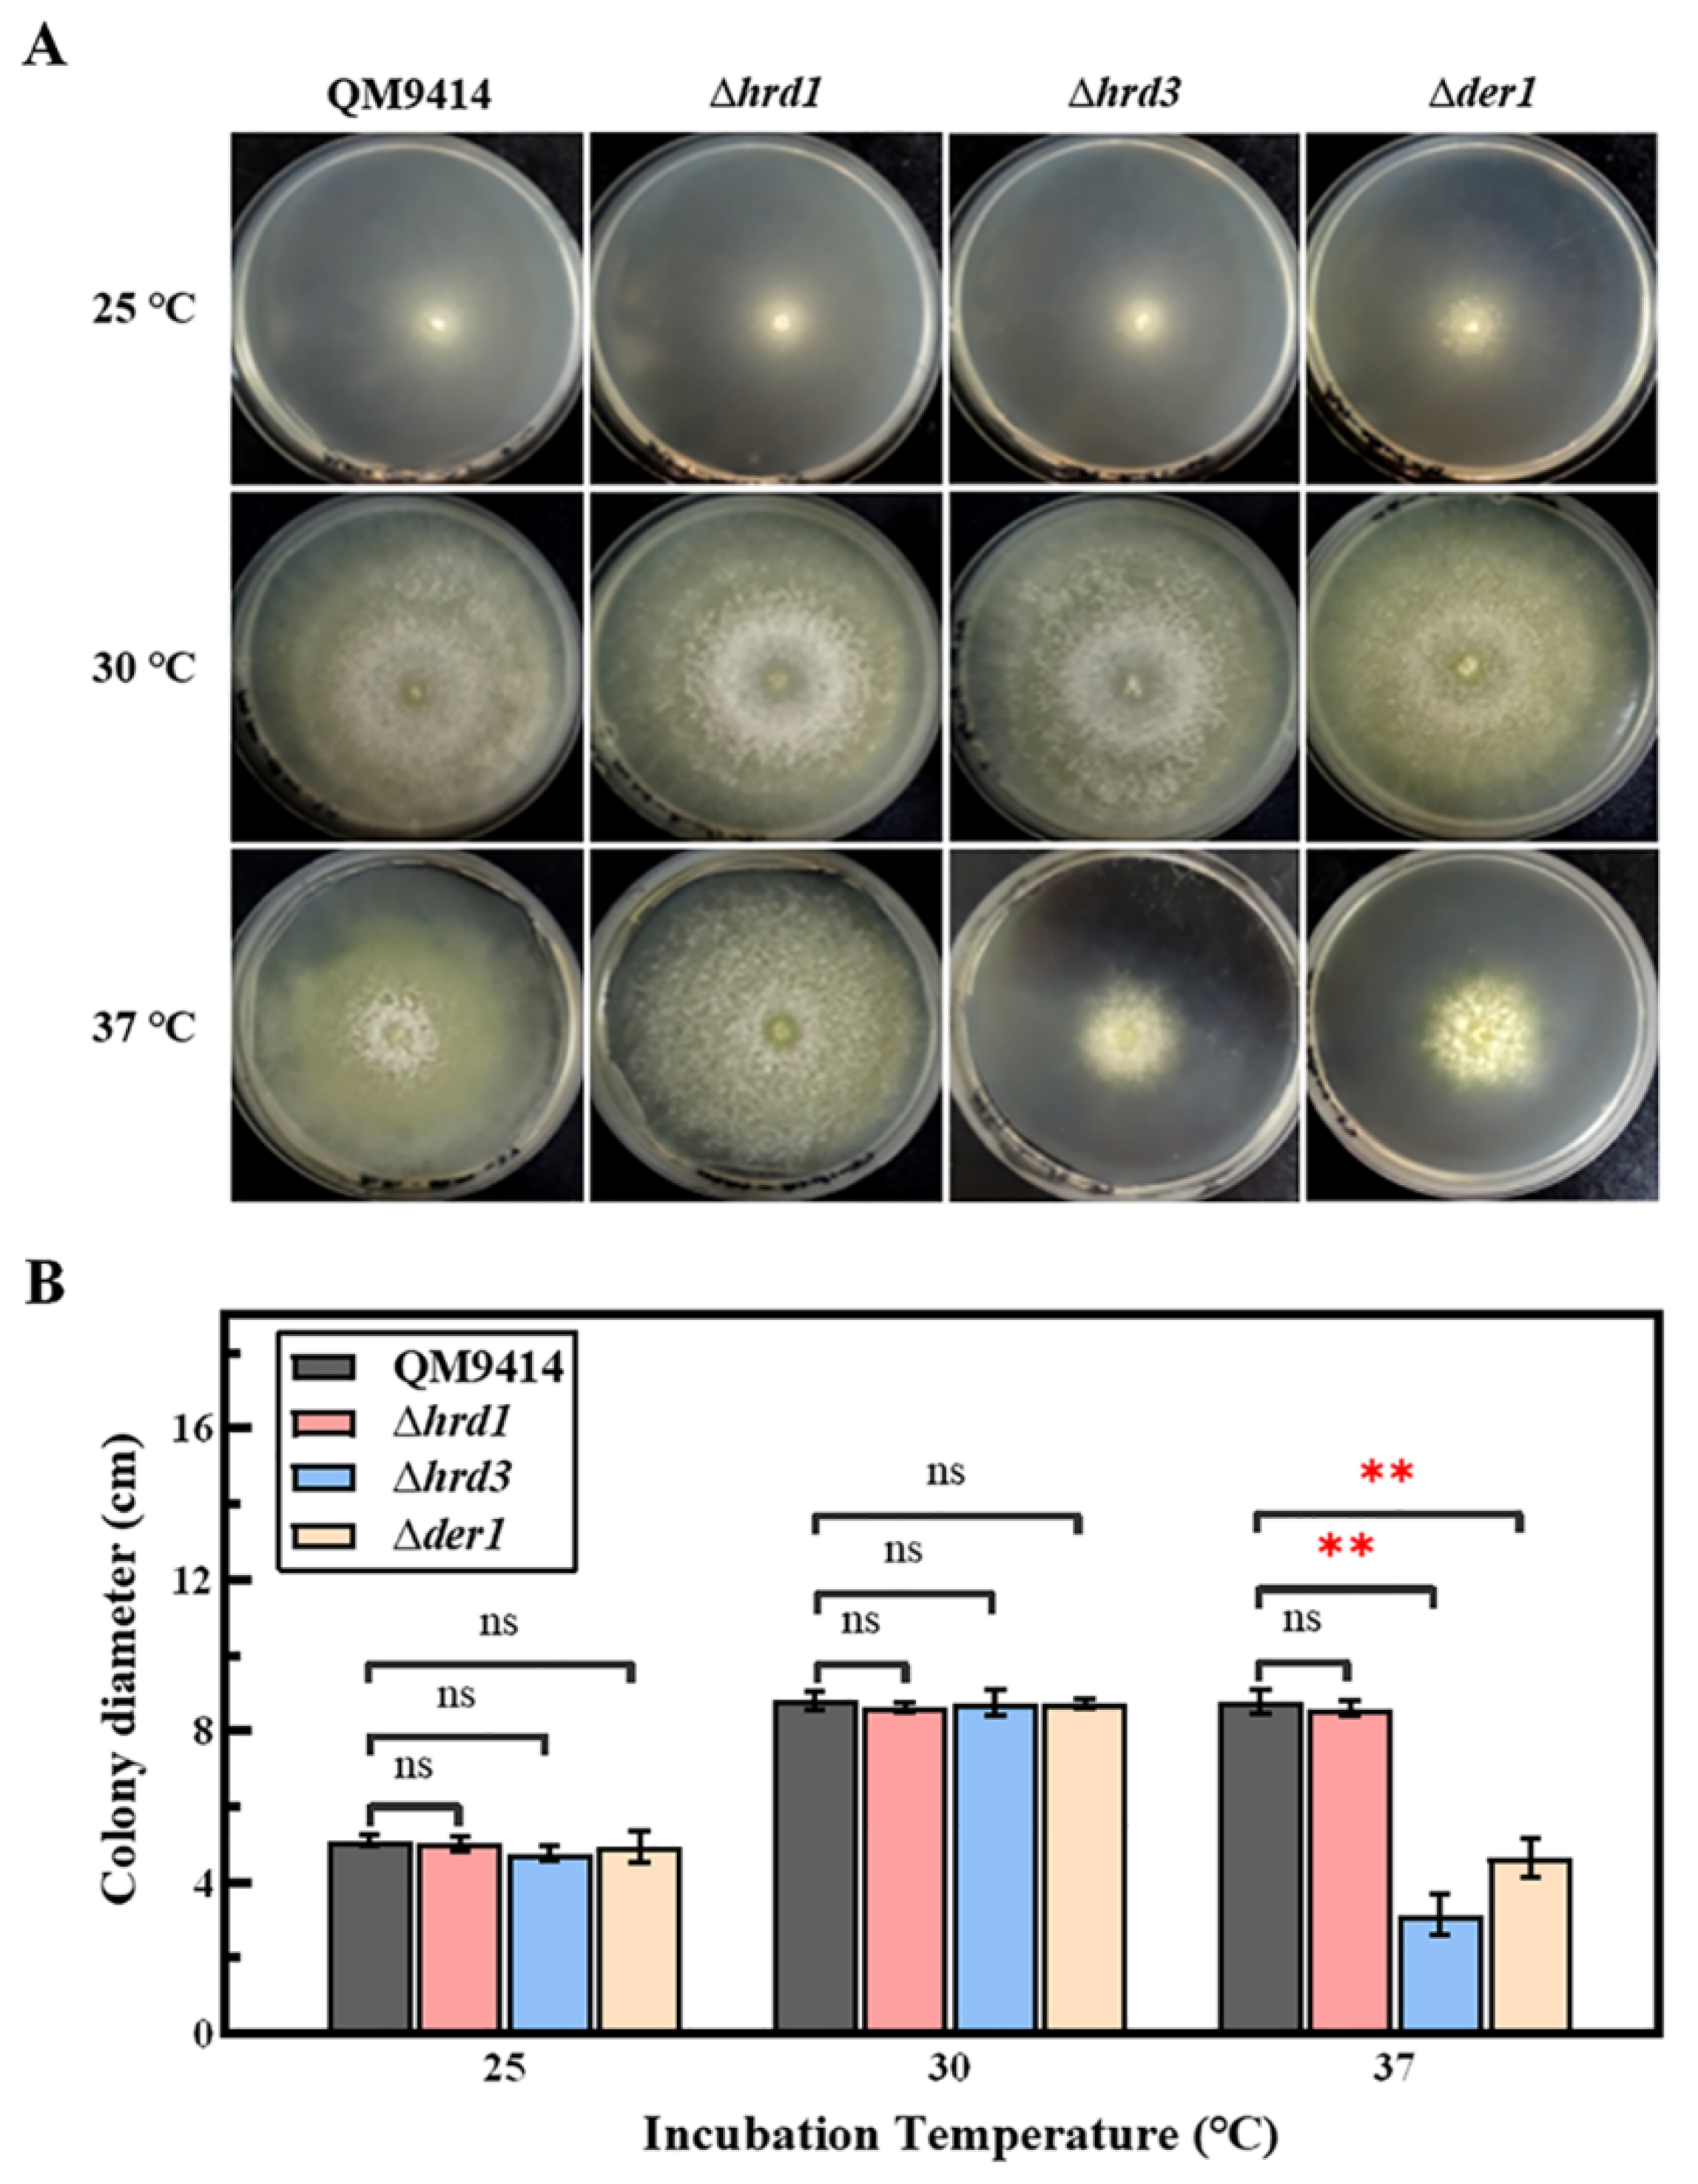
Jof 09 00074 g003 Jof 09 00074 g003

The ERAD Pathway Participates in Fungal Growth and Cellulase Secretion in Trichoderma reesei
Abstract
1. Introduction
2. Materials and Methods
2.1. Fungal Strains and Culture Conditions
2.2. Construction of the ERAD-Related Gene Deletion Strains
2.3. Phenotypic Analysis of Knockout Strains under Pressure
2.4. Cellulase Activity Assays
2.5. Total RNA Extraction and Real-Time Fluorescence Quantitative PCR
3. Results
3.1. The ERAD-Deficient Mutants Displayed Severe Growth Defects in Response to the Increased ER Stress
3.2. Cell Wall Stability of the ERAD-Deficient Mutants Was Decreased under ER Pressure
3.3. Thermal Tolerance of the ERAD-Deficient Mutants Was Reduced at High Temperature
3.4. The ERAD Pathway Deficiency Affected the Secretion of Cellobiohydrolase and β-Glucosidase
3.5. The ERAD Pathway Deficiency Triggered the Pressure Response in the ER
3.6. The ERAD Pathway Deficiency Resulted in Downregulating the Transcription of the β-Glucosidase-Coding Gene bgl1
4. Discussion
Supplementary Materials
Author Contributions
Funding
Institutional Review Board Statement
Informed Consent Statement
Data Availability Statement
Acknowledgments
Conflicts of Interest
References
- Liu, G.; Qu, Y. Integrated engineering of enzymes and microorganisms for improving the efficiency of industrial lignocellulose deconstruction. Eng. Microbiol. 2021, 1, 100005. [Google Scholar] [CrossRef]
- Garvey, M.; Klose, H.; Fischer, R.; Lambertz, C.; Commandeur, U. Cellulases for biomass degradation: Comparing recombinant cellulase expression platforms. Trends Biotechnol. 2013, 31, 581–593. [Google Scholar] [CrossRef] [PubMed]
- Filiatrault-Chastel, C.; Heiss-Blanquet, S.; Margeot, A.; Berrin, J.G. From fungal secretomes to enzymes cocktails: The path forward to bioeconomy. Biotechnol. Adv. 2021, 52, 107833. [Google Scholar] [CrossRef] [PubMed]
- Xue, X.; Wu, Y.; Qin, X.; Ma, R.; Luo, H.; Su, X.; Yao, B. Revisiting overexpression of a heterologous β-glucosidase in Trichoderma reesei: Fusion expression of the Neosartorya fischeri Bgl3A to cbh1 enhances the overall as well as individual cellulase activities. Microb. Cell Fact. 2016, 15, 122. [Google Scholar] [CrossRef]
- Kubicek, C.P.; Mikus, M.; Schuster, A.; Schmoll, M.; Seiboth, B. Metabolic engineering strategies for the improvement of cellulase production by Hypocrea jecorina. Biotechnol. Biofuels. 2009, 2, 19. [Google Scholar] [CrossRef]
- Yan, S.; Xu, Y.; Yu, X.W. From induction to secretion: A complicated route for cellulase production in Trichoderma reesei. Bioresour. Bioprocess. 2021, 8, 107. [Google Scholar] [CrossRef]
- de Ruijter, J.C.; Koskela, E.V.; Frey, A.D. Enhancing antibody folding and secretion by tailoring the Saccharomyces cerevisiae endoplasmic reticulum. Microb. Cell Fact. 2016, 15, 87. [Google Scholar] [CrossRef]
- Voorhees, R.M.; Hegde, R.S. Toward a structural understanding of co-translational protein translocation. Curr. Opin. Cell Biol. 2016, 41, 91–99. [Google Scholar] [CrossRef]
- Ellgaard, L.; Molinari, M.; Helenius, A. Setting the standards: Quality control in the secretory pathway. Science 1999, 286, 1882–1888. [Google Scholar] [CrossRef]
- Lederkremer, G.Z. Glycoprotein folding, quality control and ER-associated degradation. Curr. Opin. Struct. Biol. 2009, 19, 515–523. [Google Scholar] [CrossRef]
- Valkonen, M.; Penttilä, M.; Saloheimo, M. The ire1 and ptc2 genes involved in the unfolded protein response pathway in the filamentous fungus Trichoderma reesei. Mol. Genet. Genomics 2004, 272, 443–451. [Google Scholar] [CrossRef] [PubMed]
- Saloheimo, M.; Valkonen, M.; Penttilä, M. Activation mechanisms of the HAC1-mediated unfolded protein response in filamentous fungi. Mol. Microbiol. 2003, 47, 1149–1161. [Google Scholar] [CrossRef] [PubMed]
- Haynes, C.M.; Titus, E.A.; Cooper, A.A. Degradation of misfolded proteins prevents ER-derived oxidative stress and cell death. Mol. Cell. 2004, 15, 767–776. [Google Scholar] [CrossRef]
- Hirsch, C.; Gauss, R.; Horn, S.C.; Neuber, O.; Sommer, T. The ubiquitylation machinery of the endoplasmic reticulum. Nature 2009, 458, 453–460. [Google Scholar] [CrossRef]
- Pisa, R.; Rapoport, T.A. Disulfide-crosslink analysis of the ubiquitin ligase Hrd1 complex during endoplasmic reticulum-associated protein degradation. J. Biol. Chem. 2022, 298, 102373. [Google Scholar] [CrossRef]
- Peterson, B.G.; Glaser, M.L.; Rapoport, T.A.; Baldridge, R.D. Cycles of autoubiquitination and deubiquitination regulate the ERAD ubiquitin ligase Hrd1. eLife 2019, 8, e50903. [Google Scholar] [CrossRef] [PubMed]
- Gauss, R.; Sommer, T.; Jarosch, E. The Hrd1p ligase complex forms a linchpin between ER-lumenal substrate selection and Cdc48p recruitment. EMBO J. 2006, 25, 1827–1835. [Google Scholar] [CrossRef] [PubMed]
- Zattas, D.; Adle, D.J.; Rubenstein, E.M.; Hochstrasser, M. N-terminal acetylation of the yeast Derlin Der1 is essential for Hrd1 ubiquitin-ligase activity toward luminal ER substrates. Mol. Biol. Cell. 2013, 24, 890–900. [Google Scholar] [CrossRef]
- Hitt, R.; Wolf, D.H. Der1p, a protein required for degradation of malfolded soluble proteins of the endoplasmic reticulum: Topology and Der1-like proteins. FEMS Yeast Res. 2004, 4, 721–729. [Google Scholar] [CrossRef]
- Fleißner, A.; Dersch, P. Expression and export: Recombinant protein production systems for Aspergillus. Appl. Microbiol. Biotechnol. 2010, 87, 1255–1270. [Google Scholar] [CrossRef]
- Shen, L.; Gao, J.; Wang, Y.; Li, X.; Liu, H.; Zhong, Y. Engineering the endoplasmic reticulum secretory pathway in Trichoderma reesei for improved cellulase production. Enzyme Microb. Technol. 2021, 152, 109923. [Google Scholar] [CrossRef] [PubMed]
- Besada-Lombana, P.B.; Da Silva, N.A. Engineering the early secretory pathway for increased protein secretion in Saccharomyces cerevisiae. Metab. Eng. 2019, 55, 142–151. [Google Scholar] [CrossRef] [PubMed]
- Travers, K.J.; Patil, C.K.; Wodicka, L.; Lockhart, D.J.; Weissman, J.S.; Walter, P. Functional and genomic analyses reveal an essential coordination between the unfolded protein response and ER-associated degradation. Cell 2000, 101, 249–258. [Google Scholar] [CrossRef] [PubMed]
- Jacobs, D.I.; Olsthoorn, M.M.; Maillet, I.; Akeroyd, M.; Breestraat, S.; Donkers, S.; van der Hoeven, R.A.; van den Hondel, C.A.; Kooistra, R.; Lapointe, T.; et al. Effective lead selection for improved protein production in Aspergillus niger based on integrated genomics. Fungal Genet. Biol. 2009, 46, S141–S152. [Google Scholar] [CrossRef] [PubMed]
- Carvalho, N.D.; Arentshorst, M.; Kooistra, R.; Stam, H.; Sagt, C.M.; van den Hondel, C.A.; Ram, A.F. Effects of a defective ERAD pathway on growth and heterologous protein production in Aspergillus niger. Appl. Microbiol. Biotechnol. 2011, 89, 357–373. [Google Scholar] [CrossRef]
- Penttilä, M.; Nevalainen, H.; Rättö, M.; Salminen, E.; Knowles, J. A versatile transformation system for the cellulolytic filamentous fungus Trichoderma reesei. Gene 1987, 61, 155–164. [Google Scholar] [CrossRef]
- Qian, Y.; Zhong, L.; Hou, Y.; Qu, Y.; Zhong, Y. Characterization and Strain Improvement of a Hypercellulytic Variant, Trichoderma reesei SN1, by Genetic Engineering for Optimized Cellulase Production in Biomass Conversion Improvement. Front. Microbiol. 2016, 7, 1349. [Google Scholar] [CrossRef]
- Yu, J.H.; Hamari, Z.; Han, K.H.; Seo, J.A.; Reyes-Domínguez, Y.; Scazzocchio, C. Double-joint PCR: A PCR-based molecular tool for gene manipulations in filamentous fungi. Fungal Genet. Biol. 2004, 41, 973–981. [Google Scholar] [CrossRef]
- Gruber, F.; Visser, J.; Kubicek, C.P.; de Graaff, L.H. The development of a heterologous transformation system for the cellulolytic fungus Trichoderma reesei based on a pyrG-negative mutant strain. Curr. Genet. 1990, 18, 71–76. [Google Scholar] [CrossRef]
- Pakula, T.M.; Laxell, M.; Huuskonen, A.; Uusitalo, J.; Saloheimo, M.; Penttilä, M. The effects of drugs inhibiting protein secretion in the filamentous fungus Trichoderma reesei. Evidence for down-regulation of genes that encode secreted proteins in the stressed cells. J. Biol. Chem. 2003, 278, 45011–45020. [Google Scholar] [CrossRef]
- Wang, Y.; Kim, S.G.; Wu, J.; Yu, S.; Kang, K.Y.; Kim, S.T. Proteasome Inhibitors Affect Appressorium Formation and Pathogenicity of the Rice Blast Fungus, Magnaporthe oryzae. Plant Pathol. J. 2011, 27, 225–231. [Google Scholar] [CrossRef][Green Version]
- Ram, A.F.; Klis, F.M. Identification of fungal cell wall mutants using susceptibility assays based on Calcofluor white and Congo red. Nat. Protoc. 2006, 1, 2253–2256. [Google Scholar] [CrossRef] [PubMed]
- Qian, Y.; Zhong, L.; Gao, J.; Sun, N.; Wang, Y.; Sun, G.; Qu, Y.; Zhong, Y. Production of highly efficient cellulase mixtures by genetically exploiting the potentials of Trichoderma reesei endogenous cellulases for hydrolysis of corncob residues. Microb. Cell Fact. 2017, 16, 207. [Google Scholar] [CrossRef] [PubMed]
- Ghose, T.K. Measurement of cellulase activities. Pure Appl. Chem. 1987, 59, 257–268. [Google Scholar] [CrossRef]
- Murray, P.; Aro, N.; Collins, C.; Grassick, A.; Penttilä, M.; Saloheimo, M.; Tuohy, M. Expression in Trichoderma reesei and characterisation of a thermostable family 3 beta-glucosidase from the moderately thermophilic fungus Talaromyces emersonii. Protein Expr. Purif. 2004, 38, 248–257. [Google Scholar] [CrossRef]
- Livak, K.J.; Schmittgen, T. Analysis of relative gene expression data using real-time quantitative PCR and the 2−ΔΔCT Method. Methods 2001, 25, 402–408. [Google Scholar] [CrossRef]
- Krishnan, K.; Feng, X.; Powers-Fletcher, M.V.; Bick, G.; Richie, D.L.; Woollett, L.A.; Askew, D.S. Effects of a defective endoplasmic reticulum-associated degradation pathway on the stress response, virulence, and antifungal drug susceptibility of the mold pathogen Aspergillus fumigatus. Eukaryot. Cell. 2013, 12, 512–519. [Google Scholar] [CrossRef]
- Williams, J.A.; Hou, Y.; Ni, H.M.; Ding, W.X. Role of Intracellular Calcium in Proteasome Inhibitor-Induced Endoplasmic Reticulum Stress, Autophagy, and Cell Death. Pharm. Res. 2013, 30, 2279–2289. [Google Scholar] [CrossRef]
- Feng, X.; Krishnan, K.; Richie, D.L.; Aimanianda, V.; Hartl, L.; Grahl, N.; Powers-Fletcher, M.V.; Zhang, M.; Fuller, K.K.; Nierman, W.C.; et al. HacA-independent functions of the ER stress sensor IreA synergize with the canonical UPR to influence virulence traits in Aspergillus fumigatus. PLoS Pathog. 2011, 7, e1002330. [Google Scholar] [CrossRef]
- Richie, D.L.; Hartl, L.; Aimanianda, V.; Winters, M.S.; Fuller, K.K.; Miley, M.D.; White, S.; McCarthy, J.W.; Latgé, J.P.; Feldmesser, M.; et al. A role for the unfolded protein response (UPR) in virulence and antifungal susceptibility in Aspergillus fumigatus. PLoS Pathog. 2009, 5, e1000258. [Google Scholar] [CrossRef]
- Feldeverd, E.; Porter, B.W.; Yuen, C.Y.L.; Iwai, K.; Carrillo, R.; Smith, T.; Barela, C.; Wong, K.; Wang, P.; Kang, B.H.; et al. The Arabidopsis Protein Disulfide Isomerase Subfamily M Isoform, PDI9, Localizes to the Endoplasmic Reticulum and Influences Pollen Viability and Proper Formation of the Pollen Exine during Heat Stress. Front. Plant. Sci. 2020, 11, 610052. [Google Scholar] [CrossRef] [PubMed]
- Zou, G.; Shi, S.; Jiang, Y.; van den Brink, J.; de Vries, R.P.; Chen, L.; Zhang, J.; Ma, L.; Wang, C.; Zhou, Z. Construction of a cellulase hyper-expression system in Trichoderma reesei by promoter and enzyme engineering. Microb. Cell Fact. 2012, 11, 21. [Google Scholar] [CrossRef] [PubMed]
- Han, L.; Tan, Y.; Ma, W.; Niu, K.; Hou, S.; Guo, W.; Liu, Y.; Fang, X. Precision Engineering of the Transcription Factor Cre1 in Hypocrea jecorina (Trichoderma reesei) for Efficient Cellulase Production in the Presence of Glucose. Front. Bioeng. Biotechnol. 2020, 8, 852. [Google Scholar] [CrossRef]
- Starr, T.L.; Gonçalves, A.P.; Meshgin, N.; Glass, N.L. The major cellulases CBH-1 and CBH-2 of Neurospora crassa rely on distinct ER cargo adaptors for efficient ER-exit. Mol. Microbiol. 2018, 107, 229–248. [Google Scholar] [CrossRef]
- Knop, M.; Finger, A.; Braun, T.; Hellmuth, K.; Wolf, D.H. Der1, a novel protein specifically required for endoplasmic reticulum degradation in yeast. EMBO J. 1996, 15, 753–763. [Google Scholar] [CrossRef]
- Richie, D.L.; Feng, X.; Hartl, L.; Aimanianda, V.; Krishnan, K.; Powers-Fletcher, M.V.; Watson, D.S.; Galande, A.K.; White, S.M.; Willett, T.; et al. The virulence of the opportunistic fungal pathogen Aspergillus fumigatus requires cooperation between the endoplasmic reticulum-associated degradation pathway (ERAD) and the unfolded protein response (UPR). Virulence 2011, 2, 12–21. [Google Scholar] [CrossRef] [PubMed]
- Saloheimo, M.; Wang, H.; Valkonen, M.; Vasara, T.; Huuskonen, A.; Riikonen, M.; Pakula, T.; Ward, M.; Penttilä, M. Characterization of secretory genes ypt1/yptA and nsf1/nsfA from two filamentous fungi: Induction of secretory pathway genes of Trichoderma reesei under secretion stress conditions. Appl. Environ. Microbiol. 2004, 70, 459–467. [Google Scholar] [CrossRef] [PubMed][Green Version]
- Li, L.M.; Lü, S.Y.; Li, R.J. The Arabidopsis endoplasmic reticulum associated degradation pathways are involved in the regulation of heat stress response. Biochem. Biophys. Res. Commun. 2017, 487, 362–367. [Google Scholar] [CrossRef]
- Hwang, J.; Qi, L. Quality Control in the Endoplasmic Reticulum: Crosstalk between ERAD and UPR pathways. Trends Biochem. Sci. 2018, 43, 593–605. [Google Scholar] [CrossRef]
- Sun, Y.; Qian, Y.; Zhang, J.; Yao, C.; Wang, Y.; Liu, H.; Zhong, Y. Development of a novel expression platform for heterologous protein production via deleting the p53-like regulator Vib1 in Trichoderma reesei. Enzyme Microb. Technol. 2022, 155, 109993. [Google Scholar] [CrossRef]
- Wu, X.; Siggel, M.; Ovchinnikov, S.; Mi, W.; Svetlov, V.; Nudler, E.; Liao, M.; Hummer, G.; Rapoport, T.A. Structural basis of ER-associated protein degradation mediated by the Hrd1 ubiquitin ligase complex. Science 2020, 368, eaaz2449. [Google Scholar] [CrossRef] [PubMed]
- Al-Sheikh, H.; Watson, A.J.; Lacey, G.A.; Punt, P.J.; MacKenzie, D.A.; Jeenes, D.J.; Pakula, T.; Penttilä, M.; Alcocer, M.J.C.; Archer, D.B. Endoplasmic reticulum stress leads to the selective transcriptional downregulation of the glucoamylase gene in Aspergillus niger. Mol. Microbiol. 2004, 53, 1731–1742. [Google Scholar] [CrossRef] [PubMed]
- Zhou, B.; Wang, C.; Wang, B.; Li, X.; Xiao, J.; Pan, L. Identification of functional cis-elements required for repression of the Taka-amylase A gene under secretion stress in Aspergillus oryzae. Biotechnol. Lett. 2015, 37, 333–341. [Google Scholar] [CrossRef] [PubMed]

Disclaimer/Publisher’s Note: The statements, opinions and data contained in all publications are solely those of the individual author(s) and contributor(s) and not of MDPI and/or the editor(s). MDPI and/or the editor(s) disclaim responsibility for any injury to people or property resulting from any ideas, methods, instructions or products referred to in the content. |
© 2023 by the authors. Licensee MDPI, Basel, Switzerland. This article is an open access article distributed under the terms and conditions of the Creative Commons Attribution (CC BY) license (https://creativecommons.org/licenses/by/4.0/).
Share and Cite
Yao, C.; Yan, M.; Li, K.; Gao, W.; Li, X.; Zhang, J.; Liu, H.; Zhong, Y. The ERAD Pathway Participates in Fungal Growth and Cellulase Secretion in Trichoderma reesei. J. Fungi 2023, 9, 74. https://doi.org/10.3390/jof9010074
Yao C, Yan M, Li K, Gao W, Li X, Zhang J, Liu H, Zhong Y. The ERAD Pathway Participates in Fungal Growth and Cellulase Secretion in Trichoderma reesei. Journal of Fungi. 2023; 9(1):74. https://doi.org/10.3390/jof9010074
Chicago/Turabian StyleYao, Cheng, Mengjie Yan, Kehang Li, Weihao Gao, Xihai Li, Jiaxin Zhang, Hong Liu, and Yaohua Zhong. 2023. "The ERAD Pathway Participates in Fungal Growth and Cellulase Secretion in Trichoderma reesei" Journal of Fungi 9, no. 1: 74. https://doi.org/10.3390/jof9010074
APA StyleYao, C., Yan, M., Li, K., Gao, W., Li, X., Zhang, J., Liu, H., & Zhong, Y. (2023). The ERAD Pathway Participates in Fungal Growth and Cellulase Secretion in Trichoderma reesei. Journal of Fungi, 9(1), 74. https://doi.org/10.3390/jof9010074
